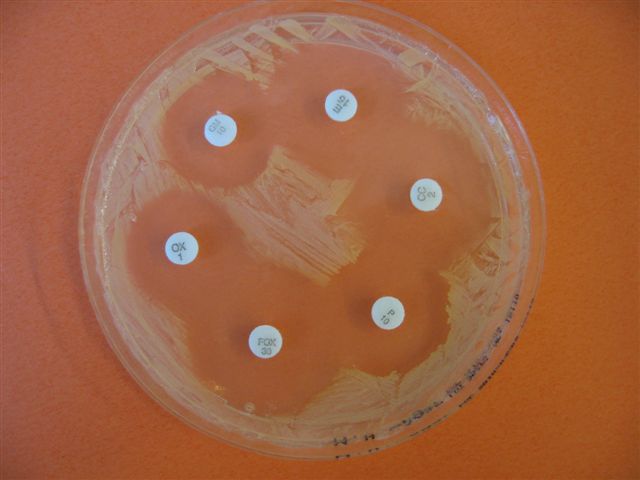
../../../_images/staph-aureus.jpg
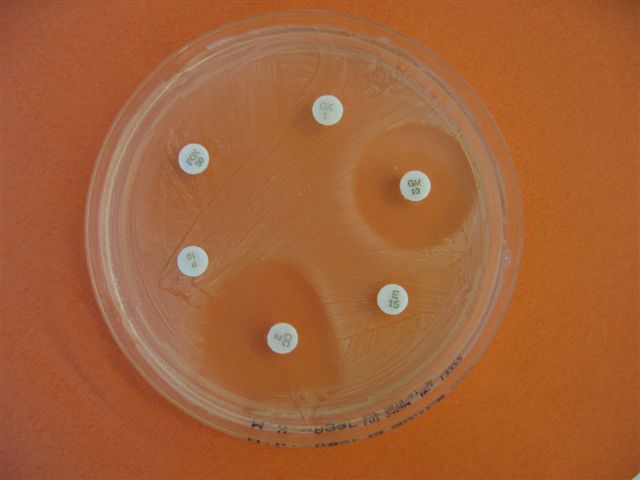
../../../_images/staph-aureus-mrsa.jpg

Hygienische Händedesinfektion#
Als hygienische Händedesinfektion wird die Desinfektion der Hände und Handgelenke mittels einer Desinfektionslösung und standardisierter Handbewegungen bezeichnet. Sie ist eine Routinemaßnahme. Ziel ist die Keimreduktion und damit die Vermeidung von Kreuzinfektionen (Unterbrechung der Infektionskette). Die herkömmliche Händewaschung entfernt nur groben Schmutz und sonstige mechanische Verunreinigungen, die Desinfektionslösung reduziert jedoch viele Keime aktiv und gezielt.
Übungen mit Fingerfarben zeigen, dass mit einer herkömmlichen Handwaschtechnik große Teile der Hand nicht mit Desinfektionsmittel benetzt werden (Fingerzwischenräume, Handgelenk, Daumenkuppe, …). Abhilfe schaffen die im Folgenden beschriebenen standardisierten Handbewegungen.
Synopsis
Kreuzinfektion: Patient 1 → Personal → Patient 2
Die Hände des Personals sind die häufigsten Keimüberträger.
Die hygienische Händedesinfektion ist vor bzw. nach jedem Patientenkontakt durchzuführen!
Fig. 89 Auf einem Nährboden wurde eine Bakterienkultur angelegt. Jedes der sechs runden Plättchen enthält ein Antibiotikum. Man kann sehen dass in der Umgebung der Plättchen keine Bakterien wachsen.#
Ch. Gabriel/KARPAT
Fig. 90 Diese Bakterien (gleicher Keim!) ignorieren 4 von 6 Antibiotika-Plättchen, d. h. die entsprechenden Antibiotika wirken nicht gegen diesen Keim. Er ist multiresistent. Die beste Maßnahme dagegen: Gar nicht erst übertragen! Ch. Gabriel/KARPAT#

Fig. 91 Oft die Folge: Amputation eines Unterschenkels mit einer nicht abheilenden, mit einem multiresistenten Staphylokokkus aureus (MRSA) infizierten, Wunde.#
Ch. Gabriel/KARPAT
Material#
Alkoholische Händedesinfektionslösung, z. B.: Sterilium, Manopronto o. ä.
Handlungsschritte#
Fig. 92 Hygienische Händedesinfektion#
[Guido Hegasy, https://www.hegasy.de; CC‑BY‑SA‑4.0]
Eine Portion alkoholisches Händedesinfektionsmittel (ca. 3 mL = 1 Hohlhand) mittels Ellenbogen aus dem Spender entnehmen; Hände und Handgelenke vollständig benetzen.
Handinnenflächen gegeneinander reiben, geschlossene Finger.
Handgelenke einreiben
Mit ineinander verschränkten Fingern Handinnenflächen gegeneinander reiben
Mit rechter Handinnenfläche linken Handrücken reiben und umgekehrt, dabei Finger ineinander verschränken
Hände ineinander verhaken und Finger gegeneinander bewegen
Daumen mit gegenüberliegender Hand vollständig umschließen und rotierend reiben. Daumenkuppen nicht vergessen!
Fingerkuppen im Handteller kreisförmig einreiben bis Alkohol verdunstet ist.
Einwirkzeit beachten! (lt. Herstellervorgaben, i.d.R. mind. 30 Sekunden)
Siehe Abbildung Hygienische Händedesinfektion.